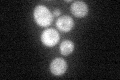
YLR215C
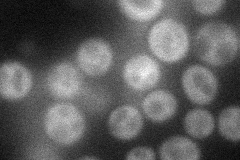
YLR215C
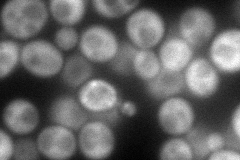
YLR215C
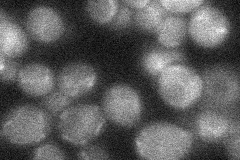
YLR215C
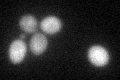
YLR215C
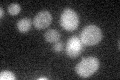
YLR215C

View description
Protein involved in nutritional control of the cell cycle; regulates abundance of the translation initiation factor eIF2; ortholog of human D123 protein
Localization:
Intensity:
Fold change:
Significance:
-
C’ GFP library in SD
cytosol31.48 -
N' NOP1pr-GFP in SD
cytosol34.0655 -
N' TEF2pr-mCherry in SD
cytosol115.324 -
N' NATIVEpr-GFP in SD
cytosol20.1905 -
N' TEF2pr-VC and Cyto-VN in SD

cytosol46.8208 -
C’ GFP library in SD+DTT
cytosol25.580.81No -
C’ GFP library in SD+H2O2

cytosol26.930.85No -
C’ GFP library in Starvation Media
cytosol33.111.05No -
C’ GFP library on the background of Pup2-DaMP

cytosol -
C’ GFP library on the background of CCT mutant

cytosol27.99850.889264No
